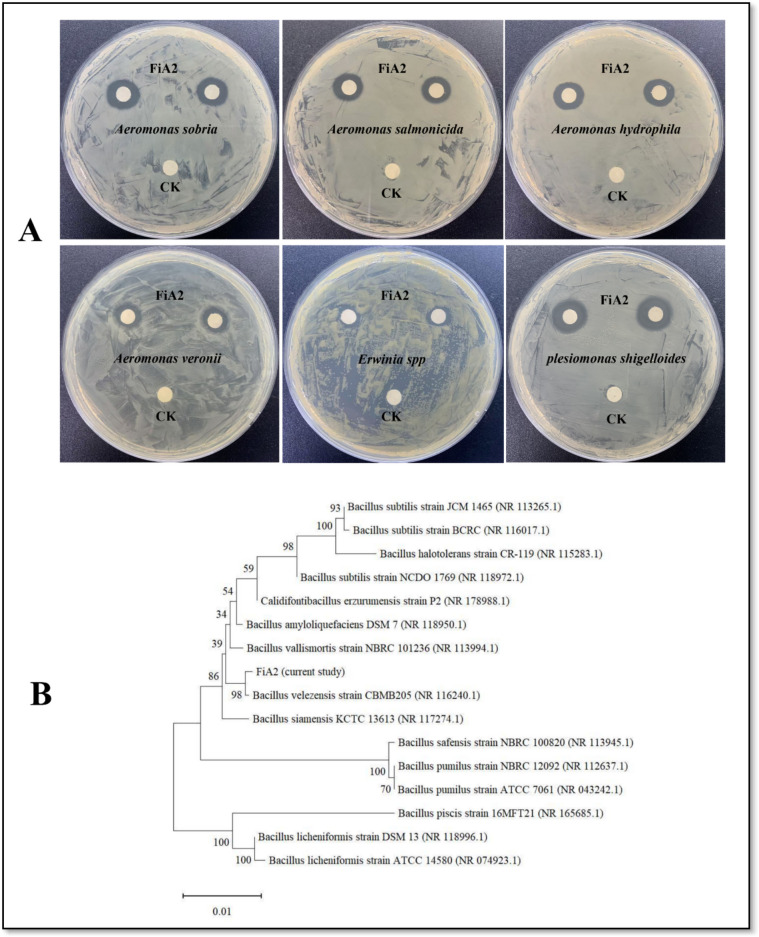

Abstract
In aquaculture, biological control of bacterial infections is a promising strategy that, aside from preventing infections, also benefits the host in several ways. In this study, a Bacillus strain FiA2 isolated from the gut of Carassius carassius (crucian carp) exhibited broad spectrums of activity against multiple aquatic bacterial pathogens. The compound with antibacterial activity was successfully separated and identified as oxydifficidin, with a m/z of 559.47. The oxydifficidin retained its activity even after being exposed to high temperatures, ultraviolet light, proteolytic enzymes, chemical reagents, and alkaline and acidic pH. Furthermore, crucian carp, when supplemented with FiA2 in diet, reduced the infection rate (post-challenged survival rate of 45%), increased the total weight gain by 15.87%, and upregulated the mRNA levels of IGF-1 and IGF-2 (P < 0.05) of muscular tissues. Similarly, the innate immune-related genes in the liver, the spleen, and the head kidney of the fish in the FiA2-supplemented group were significantly upregulated (P < 0.05). In addition, FiA2 modulated the intestinal microbiota, as observed in the FiA2 group of crucian carp; the predominant phyla were Actinobacteriota and Firmicutes, whereas in the control group, Plesiomonas dominated at the genus level. Overall, we conclude that B. velezensis FiA2, a broad-spectrum oxydifficidin-producing strain, resists infection and positively regulates the growth, immunity, and intestinal microbiota of crucian carp and thus can be implemented as a novel probiotic strain for aquaculture.
Supplementary Information
The online version contains supplementary material available at 10.1007/s12602-025-10485-7.
Keywords: B. velezensis FiA2, A. salmonicida, Probiotics, Oxydifficidin, Crucian carp
Introduction
In modern fish farming, high stocking densities and low water quality create the ideal environment for infections [1]. Fish are susceptible to parasitic, fungal, viral, and bacterial infections. Bacterial infections such as Vibriosis, Streptococcosis, Columnaris, Edwardsiellosis, and Aeromonas septicemia have been reported as a major constraint in the development of aquaculture [2, 3]. Aeromonas salmonicida is one of the oldest known fish pathogens widely distributed in all aquatic environments and causes an infection known as furunculosis. The infection results in muscular granuloma, skin ulceration, and necrosis in the liver, head kidney, spleen, and brain of the fish [4–6]. To prevent the outbreak A. salmonicida, quinolones, β-lactams, tetracyclines, and florfenicol classes of antibiotics are in common practice, but their extensive use can pose a severe risk due to the emergence of antibiotic resistance strains and the release of toxic chemicals into the environment [7–9]. Therefore, alternative preventive measures are the intense need to control causative agent of furunculosis.
Recently, alternative to antibiotics, probiotics have been widely reported in sustainable aquaculture production [10, 11]. Probiotics benefit the host by boosting its immunity, competing non-native bacteria for essential nutrients and adhesion sites, producing inhibitory substances, promoting the host’s digestion and nutrient absorption, and modulating the intestinal microbiota [11–15]. Studies [16–18] have reported the probiotic application of Bacillus species in aquaculture. Besides utilizing readily available carbon sources and resisting stress conditions, Bacillus species are natural producers of a wide range of antimicrobial metabolites with a variety of mechanism of action and practical applications [19, 20]. Bacillus species have been reported with antifungal, antiviral, antitumor, anti-inflammatory, and antibacterial applications [21–25]. Polyketides, the bioactive metabolites of several Bacillus species, are widely used against numerous infectious agents [26, 27]. Oxydifficidin is an oxidative form of difficidin, an unsaturated macrocyclic polyketide synthesized by type 1 PKS [28]. Oxydifficidin has a broad-spectrum of antibacterial activity and is widely applicable against multidrug-resistant bacteria by targeting the bacterial cell wall [29, 30]. Im et al. [19] reported the oxydifficidin production from B. methylotrophicus DR-08 with a biocontrol activity against Ralstonia solanacearum, the causative agent of tomato bacterial wilt. Oxydifficidin from B. amyloliquefaciens is active against multidrug-resistant Neisseria gonorrhoeae [31].
In this work, Bacillus velezensis FiA2, isolated from fish gut, was phenotypically and genotypically characterized. The strain has broad spectrums of antibacterial activity against aquatic bacterial pathogens. The probiotic potentials of the strain for aquaculture are investigated by using crucian carp as a model aquatic host and A. salmonicida as an aquatic bacterial pathogenic strain. Moreover, the bioactive compound is successfully separated and identified. Collectively, this study discusses the future prospects of the strain B. velezensis FiA2 as a potential probiotic for aquaculture with its ability to produce industrially important antimicrobial oxydifficidin.
Materials and Methods
Screening and Identification of FiA2
To screen the bacterium, the intestinal homogenate of crucian carp was serially diluted in sterilized PBS, and 0.1 mL of the dilutions were spread on Luria–Bertani (LB) agar plates. After incubated at 30 °C for 24 hours, different colonies were selected, sub-cultured for at least three generations, and stored at − 80 °C in a 50% (v/v) glycerol solution. For identification of the strain, its DNA was extracted by a DNA Extraction Kit (Sangon, China). The 16S rRNA of the extracted DNA was amplified by using the universal primer pairs (Table 1). After running on agarose gel, the PCR product was purified by the Gel Band Purification Kit and sequenced (Sangon, Shanghai, China). The sequence was blasted at NCBI, and the phylogenetic tree was constructed by the neighbor-joining method using MEGA X software. The strain was further evaluated by physiochemical characteristics.
Table 1.
List of primers and their sequences used in this study
| Gene | Primer 5′ – 3′ | Reference /Accession |
|---|---|---|
| 16S rRNA |
Forward: -AGAGTTTGATCCTGGCTCAG- Reverse: -CGGTTACCTTGTTACGACTT- |
11 |
| IL-8 |
Forward: -TGAAGGAATGAGTCTTAGCGG- Reverse: -ACAGTGTGAGTTTGGAGGGAA- |
12 |
| LZM |
Forward: -TGTGTCTGATGTGGCTGTGC- Reverse: -TGCACACATAGTTGCCAAGTGA- |
12 |
| IL- β |
Forward: -CAGTAAGACCAGCCTGACCTTGC- Reverse: -GCACTCAGCGTCACAGCCTTC- |
12 |
| TNF-α |
Forward:-TTATGTCGGTGCGGCCTTC- Reverse:- AGGTCTTTCCGTTGTCGCTTT – |
12 |
| β –actin |
Forward: -TGAAGATCCTGACCGAGCGT- Reverse: -GGAAGAAGAGGCAGCGGTTC- |
GT-AB020852.1 |
| C3 |
Forward: -TGTTGGAGATGAAGTGCGTT- Reverse: -CATCAGTGCCTTCTTTCAGC- |
TT-AM773828.1 |
| IgM |
Forward: -AGCTCAACCATCTGCACCAA- Reverse: -ATGTAAGCGAGTCCGCAGGT- |
AA-GU563726.1 |
| IGF-1 |
Forward:-TAGCGGTCATTTCTTCCAGG- Reverse:- CAGTGTCGGGGGAGTCAAC- |
AB757767.1 |
| IGF-2 |
Forward:-GAAAGTTTAGGAAGCAGGTGG- Reverse:- -GAACGATGGCAGGTTGTCTT- |
KP663717.1 |
*All the primers are synthesized by Sangon Biotech, Shanghai, China
Antibacterial Activity, MIC, and MBC Detection
For antibacterial activity detection, a 1% fresh culture of FiA2 was inoculated into 100 mL of LB broth containing 6% dextrin as a carbon source and incubated for 48 hours at 180 rpm and 30 °C. The collected supernatant (10,000 rpm, 10 min, 4 °C) after filtration (Millipore; 0.22 µm) was applied against the lawn of selected pathogens (S. Table 3) using disc diffusion assay. The inhibition of growth in the vicinity of the disc was measured. Furthermore, the supernatant was diluted in a sterilized LB broth and their aliquotes were made. Furthermore, each aliquote was added with 1% inoculum of A. salmonicida to detect the minimal inhibitory concentration (MIC) and minimal bactericidal concentration (MBC) of the supernatant against A. salmonicida, the target pathogenic strain of the study.
Biosafety Evaluations of FiA2
In order to implement the strain FiA2 in aquaculture as a probiotic, its in vivo and in vitro safety evaluations were made. An in vivo safety of FiA2 was demonstrated by challenging crucian carp with 0.1 mL of FiA2 (1 × 108 CFU/mL) intraperitoneally and observing the fish for any disease symptoms and fatality till the end of day 7th. In addition, in vitro safety assay was performed by a cell line experiment. Briefly, L8824 cell lines were cultured at 30 °C in DMEM (Thermo Fisher Scientific, USA) supplemented with 10% fetal calf serum and 1% penicillin–streptomycin solution. Cells were pre-incubated in 24-well plates [32], and a 24 hours fresh cell-free supernatant of FiA2 was applied onto it. The 16 hours fresh culture supernatant of A. salmonicida was used as positive control. The cells were analyzed at 24 hours of post-exposure by using Leica Microsystems, Italy.
Characterization and Stability Evaluations of Antibacterial Compound of FiA2
To characterize the antibacterial compound of FiA2, the supernatant was collected as mentioned earlier. 1 mL aliquotes of the supernatant were made and Proteolytic enzymes such as proteinase K, pepsin, and trypsin (10 mg/mL) were added to each aliquot and incubated at 37 °C for 4 hours. After incubation, the aliquots were heated at 65 °C for 10 min to inactivate the enzymes. Similarly, the supernatant was exposed to chemicals such as SDS, EDTA, and urea (1% solution) for 4 hours. To study the thermal stability of the antibacterial compound, the supernatant was exposed to different temperatures (50–100 °C) for 1 hour. To analyze the effect of the pH on antibacterial compound, the supernatant was adjusted to different pH values (4–9) by using 1 N HCl or NaOH, incubated at 37 °C for 2 hours, and finally adjusted to the normal pH (6.2). To evaluate the activity of the bioactive compound, after each treatment, the supernatant was applied against the indicator strain A. salmonicida using disc diffusion assay. Untreated supernatant was used as control.
Crude Extract Preparation, Separation by HPLC and LC–MS/MS Analysis
The bioactive compound oxydifficidin in the fermented broth was evaluated as follows. A 48 hours fermented supernatant of the cultured medium was collected by centrifugation at 10,000 g and mixed with an equal proportion of n-butanol for 3 hours with random agitation at 30-min interval. The organic phase was collected, dried in a vacuum concentrator (Thermo Scientific, Waltham, USA), and dissolved in a 50% methanol solution. The 50% methanol solution containing the bioactive substances was centrifuged at 10,000 g for 10 min and filtered through 0.22-µm Millipore. The sample was loaded onto a ZORBAX SB-C18 (4.6 × 150 mm, 5 µm) column attached with high-performance liquid chromatography (Agilent 1290, Palo Alto, USA) and monitored with an ultraviolet wavelength of 230 nm. The mobile phase A was 10% (v/v) methanol, and B was 100% methanol. The elution procedure was as follows (%B): 0–3 min, 0%; 3–20 min, 0–100%; 20–26 min, 100%; 26–28 min, 100–0%; 28–30 min, 0%. All the peaks were collected, lyophilized, and dissolved in a 50% methanol solution. The peak with activity against the indicator strain A. salmonicida was identified by LC–MS/MS on the LTQ-XL (Thermo Fisher, USA). During LC–MS/MS analysis, buffer “A” was ultrapure water containing 0.1% formic acid, while elution buffer “B” was acetonitrile containing 0.1% formic acid. The column was C18 (LAVG-25005–102130, 1.0 × 150 mm, Thermo Scientific, USA). The elution profile was the same as that of HPLC analysis.
Distribution of Crucian Carps for Feeding Trials
A total of 150 healthy crucian carps (average weight, 12.75 ± 4.7 g) were equally distributed into 6 tanks (25 fish per tank), which were further divided into an experimental group (FiA2 group; 3 tanks) and the control group (CK group; 3 tanks). The volume of water in each tank was 50 L, and the temperature was maintained at 25 °C. Once acclimatized, the fish in the FiA2 group were fed with a normal diet containing the B. velezensis FiA2 strain (1 × 108 CFU/mL/gram), while the CK group diet contained sterilized 0.9% saline only. After 30 days of feeding trials, nine fish from each group were randomly collected, and three different homogenates consisting of three different fish of the same group were made. Thus, a total of six homogenates (three of each group) were sent to Beijing Allwegene Technology (Beijing, China) for intestinal microbiota analysis. Furthermore, six fish from each group were randomly collected, and RNA extraction was made from their head kidney, spleen, liver, and muscular tissues.
RNA Extraction and cDNA Synthesis
The head kidney, spleen, liver, and muscular tissues (50 mg) were used to extract the total RNA [33]. In brief, 1 mL of TRIzol reagent (Takara, Japan) was added to the corresponding tissues and vigorously passed through the needle of a 5mL syringe to make its homogenate. The homogenate was transferred into a 1.5 mL RNase-free tube, 0.2 mL of trichloromethane was added, shaken vigorously for 15 s, and kept for 10 min on the ice. The aqueous phase after centrifugation (12,000 rpm; 10 min; 4 °C) was added with an equal volume of the isopropanol and subsequently kept for 10 min on the ice to precipitate the RNA. After final centrifugation (12,000 rpm; 10 min; 4 °C), the RNA was washed twice with 75% ethanol and finally dissolved in the RNase free water. The quality and quantity of RNA were assessed by 2% agarose gel electrophoresis and a NanoDrop 2000 spectrophotometer (Thermo Scientific, Waltham, USA), respectively. The RNA extracted from all the selected organs was reverse transcribed to cDNA by Evo M-MLV RT Mix Kit (Accurate Biotechnology, China) following manufacturer instructions. The primers used for the detection of expression levels of immune and growth-related genes are listed in S. Table 3.
Growth Performance
The role of FiA2 in growth performance of crucian carp was evaluated as the weight gain rate (WGR) and expression levels of insulin-like growth factor (IGF-1 and IGF-2) genes in muscular tissues after a feeding trial of 30 days, following our previous work [11].
W0 and Wt represent the average weights of fish in each group at the start and end of the experiment, respectively.
Resistance to Infection
The resistance of crucian carp of both FiA2 and CK groups to the infectious A. salmonicida after a feeding trials of 30 days was evaluated in terms of percentage survival rate. A. salmonicida diluted to a concentration of 1 × 108 CFU/mL in a sterilized saline (0.9%) and the fish both in FiA2 and CK groups (20 fish per group) were intraperitoneally challenged with 0.1 mL of it and monitored for 7 days. The relative percent survival (RPS) against A. salmonicida was evaluated by the following formula:
FiA2 and Immunity of Crucian Carp
To detect the effects of the probiotic B. velezensis FiA2 on the immunity of crucian carp, the relative expression levels of the immune-related genes in the head kidney, liver, and spleen were evaluated by qRT-PCR. The quantitative PCR instrument used was a 7500 Real-Time PCR System (Applied Biosystems, USA). The system reaction volume was adjusted to 10 µL: SYBR® Green Master Mix, 5 µL; cDNA, 1 µL; forward primer (10 µM/L), 0.5 µL; reverse primer (10 µM/L), 0.5 µL; and sterilized double distilled water, 3 µL. The SYBR Green II dye method has a cycling profile of 50 °C for 2 min and 95 °C for 10 min followed by 40 cycles of 15 s at 95 °C and 1 min at 50 °C. The 2−ΔΔCt method was used to analyze the relative expression level of each gene. The β-actin gene was used as an internal control.
The High-Throughput Sequence and Data Analysis
Using universal primer pairs 338F (5′-ACTCCTACGGGAGGCAGCAG-3′) and 806R (5′-GGACTACNNGGGTATCTAAT-3′), the hypervariable region (V3-V4) of the 16S sRNA gene of the intestinal DNA samples was amplified by using the Mastercycler Gradient (Eppendorf, Germany) with a cycling profile of initial denaturation at 95 °C for 5 min, followed by 28 cycles of 95 °C for 45 s, 55 °C for 50 s, and 72 °C for 45 s with a final extension of 72 °C for 10 min. The PCR products were purified by the Agencourt AMPure XP Kit (Beckman Coulter, USA). The Illumina MiSeq System (Illumina, Inc., USA) platform at Beijing Allwegene Technology Co., Ltd. performed the deep sequencing of the samples. The raw data was filtered and spliced; the sequences containing ambiguous bases and sequences of shorter length (< 230 bp) were removed from consideration by using PEAR and VSEARC, respectively [34, 35]. Successfully qualified sequences having 97% similarity were clustered into operational taxonomic units (OTUs) by UPARSE [36]. For the generation of rarefaction curves and diversity indices based on the OTUs information, the Quantitative Insights Into Microbial Ecology (QIIME) pipeline was used [37]. The β-diversity distance matrix between samples was calculated using the Bray Curtis algorithms and plotted PCoA. LEfSe analysis was made by Python software.
Antibiotic Susceptibility Assay
The susceptibility of the FiA2 was evaluated to 16 antibiotics of different classes (Table 2) by using disc diffusion assay [38]. The susceptibility of the strain was measured as the inhibitory zone of the corresponding antibiotic against the strain and represented as sensitive, intermediate, and resistant following the National Committee for Clinical Laboratory Standards [39].
Table 2.
Profile of antibiotics susceptibility of B. velezensis FiA2
| Drug class | Drug | µg/ml | Inhibition zone | Category |
|---|---|---|---|---|
| Macrolide | Erythromycin | 15 | 22.23 ± 0.15 | S |
| Beta-lactam | Ampicillin | 10 | 22.20 ± 0.10 | S |
| Meropenem | 10 | 17.43 ± 0.15 | I | |
| Aminoglycoside | Gentamicin | 10 | 24.56 ± 0.25 | S |
| Kanamycin | 30 | 24.06 ± 0.10 | S | |
| Tetracycline | Tetracycline | 30 | 24.76 ± 0.35 | S |
| Doxycycline | 30 | 27.16 ± 0.15 | S | |
| Quinolones |
Ciprofloxacin Chloramphenicol Norfloxacin |
5 30 10 |
32.46 ± 0.15 29.06 ± 0.05 18.26 ± 0.10 |
S S I |
| Fluoroquinolone | Enrofloxacin | 10 | 33.50 ± 0.25 | S |
| Glycopeptide | Vancomycin | 30 | 24.26 ± 0.30 | S |
| Rifamycin | Rifampicin | 5 | 20.20 ± 0.25 | I |
| Cephalosporin | Ceftazidime | 30 | 24.33 ± 0.15 | S |
| Others |
Polymyxin B Trimethoprim |
30 25 |
0 31.26 ± 0.20 |
R S |
*For each antibiotic the inhibition zone (diameter in mm) was measured and expressed as susceptible, S (zone ≥ 21 mm); intermediate, I (zone = 16–20 mm); and resistance, R (zone < 15 mm)
Statistical Analysis
All data were statistically analyzed by GraphPad Prism (9.3) software and presented as the mean ± SE of the mean (SEM). The independent samples t-test was used to calculate significant differences. A value of P < 0.05 was considered statistically significant. ***P < 0.001; **P < 0.01; *P < 0.05.
Data Availability
The data of the manuscript is previously unpublished. The 16S rRNA gene sequence is available in the NCBI database (Accession No: PP989326), while reads of gut microbiota are available in the NCBI Short Read Archive database (Accession No. PRJNA1133171).
Results
Identification and Characterization of FiA2
Based on the broad spectrum of antibacterial activity against multiple aquatic bacterial pathogens, FiA2 was selected for further delineation. The blast analysis of 16S rRNA gene sequence (1436 bp) at NCBI and phylogenetic analysis by MEGA X revealed maximum homology with Bacillus velezensis (Fig. 2B). Furthermore, the physiological and biochemical characteristics (Fig. 1; S. Table 4) of the strain were consistent with the characteristics of Bacillus velezensis BvL03 [18]. We considered that FiA2 is a novel B. velezensis strain and is therefore given the name B. velezensis FiA2.
Fig. 2.
The antibacterial spectrum and phylogenetic tree of B. velezensis FiA2. A The antibacterial activity of 48 hours supernatant of FiA2 against aquatic bacterial pathogens by disc diffusion assay. B The phylogenetic tree of FiA2 based on 16S rRNA gene sequence constructed by the neighbor-joining method. The numbers at the nodes indicate the percentage occurrences among 1000 bootstrap values
Fig. 1.
Physiological characteristics of the probiotics B. velezensis FiA2 strain. A Growth pattern and colony morphology on LB agar plate; B growth in optimal broth medium; C gram staining micrograph (scale bars 20 µm); D phase contrast micrograph; the arrows indicate the spores of FiA2 (scale bars 20 µm); E and F scanning electronic micrographs
Antibacterial Activity, MIC, and MBC of FiA2
The fermented cell-free supernatant of B. velezensis FiA2 was evaluated against selected aquatic bacterial pathogens. The inhibitory diameter against A. salmonicida was recorded as 12.7 ± 0.2 mm (Fig. 2A). The determined minimal inhibitory concentration (MIC) and minimal bactericidal concentration (MBC) of the cell-free supernatant against A. salmonicida were 15% and 16%, respectively (S. Figure 11).
Safety of FiA2 for Aquaculture
Challenged crucian carp with FiA2 have no disease symptoms or fatality, affirming the in vivo safety of the strain for aquatic hosts. The in vitro analysis revealed that FiA2 could not induce any morphological changes or cytotoxic effects on L8824 cell lines (Fig. 3).
Fig. 3.
Biosafety evaluations of the B. velezensis FiA2 for aquaculture. A In vivo evaluation: no hemorrhagic symptoms in FiA2 challenged crucian carp, while clear hemorrhages on skin and at the bases of gills, as indicated by the red arrows, are observed in A. salmonicida challenged crucian carp. B In vitro evaluation: compared to A. salmonicida, the symmetry arrangement and growth behavior of L8824 cell lines are normal
Characterization and Stability Evaluations of Antibacterial Compound of FiA2
The relative activity of supernatant against the indicator strain A. salmonicida at high temperature (100 °C), acidic pH (4), alkaline pH (9), UV, pepsin, trypsin, proteinase K, urea, EDTA, and SDS was determined as 79.33%, 87.98%, 98.17%, 99.48%, 98.72%, 97.42%, 99.48, 100%, 99.48%, and 83.37%, respectively. These results indicate that the bioactive compound of the strain is highly stable.
HPLC and LC–MS Analysis of the Crude Extract
Before the analysis, the crude extract of B. velezensis FiA2 was checked for its activity against the selected pathogens by the well diffusion method, which confirmed the presence of the antibacterial substance in the crude extract. As shown in Fig. 4A, the HPLC chromatogram revealed 13 different peaks from the crude extract, among which the peak 11 with a retention time of 16.75 min exhibited activity against A. salmonicida. After second round of separation, It was detected that bioactive peak 11 contains four peaks, in which 11C possesses activity against A. salmonicida (Fig. 4D). The 11C was further analyzed by LC–MS/MS and determined with a m/z of 559.47 (Fig.5B), previously reported as oxydifficidin from B. methylotrophicus [19].
Fig. 4.
HPLC analysis and antibacterial activity of the crude extract and bioactive peaks. A Chromatography spectra of 1-butanol crude extract of FiA2. B Peaks 1–13 applied against A. salmonicida; the peak 11 containing bioactive compound have retention time of 16.838 min. C Secondary separation and chromatography spectra of the bioactive Peak 11. D Peaks 11A–11D of the peak 11, applied against A. salmonicida
Fig. 5.
LC–MS analysis of the purified bioactive compound produced by B. velezensis FiA2. A The mass spectra shows a molecular ion peak at m/z 559.47 corresponds to the protonated oxydifficidin. B Secondary mass spectrometry of bioactive compound oxydifficidin
Effect of FiA2 on the Growth of Crucian Carp
The weight gain rate in the FiA2 supplemented group (15.87%) was comparatively higher than the control group (8.44%). Alongside, Fig. 6A revealed that FiA2 significantly (P < 0.05) upregulated the IGF-1 and IGF-2 levels in the muscular tissue of crucian carp.
Fig. 6.

The influence of FiA2 on A the expression level of IGF-1 and IGF-2 genes of muscular tissues and B the survival rate in the FiA2 group compared with the control group after being challenged with A. salmonicida. Each gene expression level in the control group was regarded as 1. *P < 0.05, **P < 0.01 (n = 4)
FiA2 Resistance to Infection in Crucian Carp
Figure 6B illustrates that by challenging crucian carp with A. salmonicida, the survival rates in FiA2 and CK groups were 45% and 18%, respectively. The determined relative percentage survival (RPS) rate in the FiA2 supplement group was 31.25%, which indicates that FiA2 provides protection to aquatic hosts against infectious agents.
Expression Levels of Immune-Related Genes
The expression levels of immune-related genes in the spleen, liver, and head kidney were evaluated after a feeding trial of 30 days. As shown in Fig. 7, FiA2-supplemented fish have significantly higher expression of IL-8 in all three selected organs, while IgM showed a higher expression level only in the spleen. The IL-1β and LYZ were highly expressed in the head kidney and liver, while in the spleen, their expressions were not significantly changed. C3 showed a higher expression level in the head kidney and spleen. Likewise, along in the spleen, TNF-α also revealed significantly higher expression in the liver of fish supplemented with FiA2.
Fig. 7.
The relative expression levels of immune-related genes in A head kidney, B liver, and C spleen of crucian carp after 30 days of supplementation of FiA2 in diet. Each gene expression level in the control group was regarded as 1. *P < 0.05, **P < 0.01 (n = 4)
Influence of FiA2 on Intestinal Microbiota of Crucian Carp
A total of 445,750 valid sequences and 518 OTUs were obtained from samples of both groups. The valid reads range from 65,229 to 77,487, while OTUs are in the range from 232 to 317. Both groups FiA2 and CK shared 51.35% of the OTUs, while 28.76% and 19.88% of the total OTUs were unique to the FiA2 and CK groups, respectively. The total OTUs are deduced into 18 phyla and 141 genera. The phyla with a relative abundance of more than 0.1% were Fusobacteriota, Actinobacteriota, Planctomycetota, Firmicutes, Patescibacteria, Verrucomicrobiota, Bacteroidota, and Proteobacteria. Crucian carp in the FiA2 group were dominated by Actinobacteriota (1.79%), Planctomycetota (3.48%), Firmicutes (1.56%), and Verrucomicrobiota (1.42%), while the predominant phyla in crucian carp of CK group were Fusobacteriota (62.28%), Bacteroidota (5.78%), and Proteobacteria (26.31%) (Fig. 8C). In FiA2 group, the alpha diversity indices such as Simpson index and Shannon index were significantly (P < 0.05) higher, while no significant difference between the two groups were observed for Chao1 and observed species indices (Fig. 9). In order to identify taxa consistently associated with crucian carp of each condition (FiA2 or CK), the microbiota were compared by using LEfSe. The results as shown in Fig. 10 reflect that FiA2 supplementation significantly promoted 27 taxa (LDA > 3.0). Among these groups are highlighted taxa for the phylum Firmicutes, the orders Bacillales, Corynebacteriales, and Gaiellales, and the genus Bacillus. In contrast, the CK group has only 12 taxa, which mainly belonged to the class Gammaproteobacteria, the orders Enterobacterales and Xanthomonadales, and the genus Plesiomonas.
Fig. 8.
The influences of FiA2 on the microbial community of crucian carp. A The rarefaction curve plots of all samples. B Venn diagram representing the shared and unique OTUs between FiA2-supplemented and control groups. C and D Comparison of relative abundance at phyla and genus levels, respectively
Fig. 9.
Boxplots of alpha-diversity indices between FiA2 and CK groups. A Chao1 index and B observed OTUs are non-significantly different, whereas C Simpson and D Shannon indices are significantly different between the two groups. Statistical analysis was made by applying the independent samples t-test
Fig. 10.
Graphical representation of LEfSe results. Comparison of LDA effect size of the significantly differentiating bacterial taxa. The histogram shows the most significantly abundant taxa in the crucian carp microbiota of FiA2 and CK groups
Antibiotic Susceptibility Assay
Table 2 shows the antibiotic susceptibility profile of the B. velezensis FiA2 evaluated for 16 antibiotics of 10 different classes. Among all the selected antibiotics, the strain was resistant to polymyxin B only. The strain was highly susceptible to enrofloxacin (33.50 ± 0.25 mm) followed by ciprofloxacin (diameter, 32.46 ± 0.15 mm). Meropenem and norfloxacin have the least zones of inhibition against the strain, with a diameter of 17.43 ± 0.15 mm and 18.26 ± 0.10 mm, respectively.
Discussion
In the current study, the antibacterial compound of the strain B. velezensis FiA2 is successfully separated and analyzed via HPLC and MS approaches, respectively. Moreover, we elucidated that B. velezensis FiA2 has practical probiotic applications using the in vitro antimicrobial activity combining with its effects on resistance to infection, the growth, immunity, and intestinal microbiota of crucian carp. Our study suggests that the strain B. velezensis FiA2 has the potential to be applied in aquaculture as a probiotic to provide protection against infectious diseases as well as benefit the aquatic host. In line with this, Zhou et al. [12] reported that probiotic Bacillus amyloliquefaciens X030 as a biological control, when supplemented in feed to grass carp, resists infections of Aeromonas hydrophila and Aeromonas veronii, significantly overexpresses the levels of C3 and IL-8 genes in the liver and head kidney and increases the relative abundance of probiotic strains (Proteobacteria, Fusobacterium, and Gemmobacter) while decreasing potential pathogenic bacteria (Aeromonas and Planctomycetes).
A previous study by Dharmaraj et al. [10] detected the inhibitory activity of B. aerophilus KADR3 against several aquatic pathogens, which includes A. hydrophila, Providencia rettgeri, and Aeromonas enteropelogenes, and further made a safety evaluation of the KADR3 by challenging and observing the disease symptoms and mortality in L. rohita. Another study reported that the cell-free supernatant of probiotics Pediococcus pentosaceus (SL001) is non-toxic to hepatic L8824 cell line of grass carp and the strain supplementation to grass carp resists against infection of A. hydrophila [11]. These studies support the attributes of our strain FiA2: non-toxicity to the hepatic L8824 cell lines, non-lethality to aquatic hosts, resistance to infection of A. salmonicida, and broad spectrum antibacterial activity against multiple aquatic pathogens.
The antibacterial activity of Bacillus species is due to the production of bioactive metabolites, which include polyketide synthases (PKS) and non-ribosomal peptide synthases (NRPS) [40]. Polyketide oxydifficidin production from Bacillus species and its antimicrobial activity have been reported by various studies. Im et al. [19] reported the oxydifficidin from B. methylotrophicus with inhibitory activity against 14 phytopathogenic bacteria. Similarly, oxydifficidin from B. amyloliquefaciens was found active against both wild-type and multidrug-resistant N. gonorrhoeae [31]. A study by Han et al. [41] reported oxydifficidin producing B. velezensis as a biocontrol against both bacterial and fungal agents of shot-hole disease (SH) in flowering cherry. These results correlate with our findings of oxydifficidin production from B. velezensis FiA2 with antibacterial activity against pathogens and its application as a biological control for aquaculture industry against infectious disease agents. Moreover, our results of high stability of oxydifficidin to high temperatures, protein-degrading chemicals and enzymes, acidic and alkaline pH, and UV are concurrent with the findings of Gao et al. [42] who reported the bioactive extract of B. velezensis V4 containing iturin, macrolactin, and difficidin which are stable at high temperature, different pH, UV, and proteases. The high stability of the oxydifficidin produced by the strain to heat, pH, chemicals, and enzymes is important for its practical applications such as feedstuff production and utilization by the host.
Many researchers have investigated the effect of probiotic strains on the growth performance of fish [43–48]. A study by Gong et al. [11] reported that probiotic Pediococcus pentosaceus (SL001) significantly upregulates the expression of IGF-1 and IGF-2 genes in the muscular tissue of grass carp after a feeding trial of 30 days. Sadat et al. [49] observed that probiotic Bacilli (Bacillus subtilis and Bacillus licheniformis) at a concentration of 1 × 108 CFU/g improved the final weight gain in whiteleg shrimp. Studies [11, 49] are supportive of the present investigations, an increase in final weight gain, and the significantly (P < 0.05) overexpressed IGF-1 and IGF-2 genes in FiA2-supplemented crucian carp, suggesting that FiA2 regulates the metabolism of the crucian carp to perform a better growth performance.
To implement for practical application, probiotics must be capable of stimulating the immune system of fish to counteract infectious agents [50, 51]. In various aquatic species, the expression level of immune-related genes, such as IgM, C3, LYZ, IL-8, TNF-α, and IL-1β, are validly evidenced for assessment of immune responses triggered by the probiotics [52, 53]. A study [54] revealed that the two probiotic strains Leuconostoc mesenteroides subsp. cremoris SMM69 and Weissella cibaria P71 overexpressed IL-1β, TNF-α, LYZ, and C3 genes in the head kidney, spleen, liver, intestine, and skin of turbot juveniles. Similarly, Bacillus amyloliquefaciens X030 (BaX030) as dietary supplementation significantly upregulated the level of IgM and IL-8 in the liver and head kidney of grass carp [12]. Our results of the differentially overexpressed IgM, C3, LYZ, IL-8, TNF-α, and IL-1β genes in various organs of crucian carp revealed that B. velezensis FiA2, when supplemented in feed, triggers the immune responses that can counteract disease causing agents and provide protection to aquatic host from infections.
Probiotics are dietary factors that have a regulatory effect on the composition of intestinal microbiota [55]. Intestinal microbiota are important to the health of the host as they are involved in nutritional metabolism and immunity against infectious agents [56]. Firmicutes besides metabolization of carbohydrates also produce secreted soluble factors and metabolites, such as short-chain fatty acids (SCFAs) that affect the function of intestinal epithelium, which results in the production of cytokines and B-cell-activating factors [57–59]. Similarly, Actinobacteriota, a major phylum of the healthy intestine of both humans and animals, has a pivotal function in the maintenance of gut homeostasis, energy production, and immune system [60]. A study of Sha et al. [61] reported the increased in the phyla Firmicutes and Actinobacteria in whiteleg shrimp after supplementing the supernatant of probiotic strain HC-2. The genus Plesiomonas causes infections in various aquatic hosts [62]. Findings of Li et al. [63] and Bera et al. [64] supported the presence of Fusobacteriota, Actinobacteriota, Planctomycetota, Firmicutes, Patescibacteria, Verrucomicrobiota, Bacteroidota, and Proteobacteria as the dominant phyla in the gut of fish healthy fish. Our results of increased abundance of Firmicutes and Actinobacteriota, while the decreased Plesiomonas in the intestine of FiA2 supplemented fish reflect the healthy gut of crucian carp with no risk of infection and a better metabolism and immunity.
Recently, probiotic strains of different origins, which include dairy products, animals, humans, food products, starter cultures, and soils, have been reported to harbor antibiotic resistance determinants that may transfer to other pathogenic bacteria that share the same intestinal habitat and develop multi-drug-resistant pathogenic strains [65]. The susceptibility of the strain FiA2 to antibiotics of different classes suggests that FiA2 does not have any resistance determinants in their genome to develop multi-drug-resistant pathogenic strains.
In summary, the results of this paper reveal that B. velezensis FiA2, an oxydifficidin-producing strain, has practical probiotic applications in crucian carp; further exploring its genome will provide ideas for synthetic approaches and development of an engineer strain that can be use as micro-ecological preparation to prevent infections in aquaculture.
Supplementary Information
Below is the link to the electronic supplementary material.
Acknowledgements
The authors extend their appreciation to the Researchers Supporting Project (RSP-2025R369), King Saud University, Riyadh, Saudi Arabia. The first author of this research as an international student is thankful to teacher Guo Liping, Liu Chenhui, and Tang Cunzhong of the International Exchange and Cooperation Department, Hunan Normal University, and Hunan Provincial Scholarship for International Student for their financial support.
Author Contribution
KT wrote the original draft. KT and HL performed the strain isolation and identification. ZX detected the antimicrobial activity. BS did the qRT-PCR and antibiotics susceptibility analysis. KT, and JR made the analysis of HPLC and LC–MS/MS. KT, AR, and AK did the comparative microbiota data analysis. SH revised the manuscript. KT and LX designed the study. SH and LX supervised the research. LX made funding acquisition. The manuscript was discussed by all the authors and approved for publication.
Funding
This research was supported by the National key Research and Development program of China (2011AA10A203) and the National Natural Science Foundation of China (31770106, 3107006). The authors extend their appreciation to the Researchers Supporting Project (RSP-2025R369), King Saud University, Riyadh, Saudi Arabia.
Data Availability
PRJNA1133171.
Declarations
Ethical Approval
The present study was approved by the ethics committee of Hunan Normal University. The animal experiments were carried out in accordance with the Guidelines for Ethical Review of Animal Welfare in China.
Competing Interest
The authors declare no competing interests.
Footnotes
The original version of this article has been updated to correct Table 1 and Acknowledgements.
Publisher's Note
Springer Nature remains neutral with regard to jurisdictional claims in published maps and institutional affiliations.
Change history
4/2/2025
The original version of this article has been updated to correct Table 1 and Acknowledgements.
Change history
4/4/2025
A Correction to this paper has been published: 10.1007/s12602-025-10531-4
References
- 1.Bentzon-Tilia M, Sonnenschein EC, Gram L (2016) Monitoring and managing microbes in aquaculture–towards a sustainable industry. Microb Biotechnol 9:576–584. 10.1111/1751-7915.12392 [DOI] [PMC free article] [PubMed] [Google Scholar]
- 2.Rohani MF, Islam SM, Hossain MK, Ferdous Z, Siddik MA, Nuruzzaman M, Padeniya U, Brown C, Shahjahan M (2022) Probiotics, prebiotics and synbiotics improved the functionality of aquafeed: upgrading growth, reproduction, immunity and disease resistance in fish. Fish Shellfish Immunol 120:569–589. 10.1016/j.fsi.2021.12.037 [DOI] [PubMed] [Google Scholar]
- 3.Irshath AA, Rajan AP, Vimal S, Prabhakaran VS, Ganesan R (2023) Bacterial pathogenesis in various fish diseases: recent advances and specific challenges in vaccine development. Vaccines 11(2):470. 10.3390/vaccines11020470 [DOI] [PMC free article] [PubMed] [Google Scholar]
- 4.Kim DH, Choi SY, Kim CS, Oh MJ, Jeong HD (2013) Low-value fish used as feed in aquaculture were a source of furunculosis caused by atypical Aeromonas salmonicida. Aquaculture 409:113–117. 10.1016/j.aquaculture.2013.05.014 [Google Scholar]
- 5.Bartkova S, Kokotovic B, Skall HF, Lorenzen N, Dalsgaard I (2017) Detection and quantification of Aeromonas salmonicida in fish tissue by real-time PCR. J Fish Dis 40:231–242. 10.1111/jfd.12505 [DOI] [PubMed] [Google Scholar]
- 6.Valderrama K, Soto-Dávila M, Segovia C, Vásquez I, Dang M, Santander J (2019) Aeromonas salmonicida infects Atlantic salmon (Salmo salar) erythrocytes. J Fish Dis 42:1601–1608. 10.1111/jfd.13077 [DOI] [PubMed] [Google Scholar]
- 7.Watts JEM, Schreier HJ, Lanska L, Hale MS (2017) The rising tide of antimicrobial resistance in aquaculture: sources, sinks and solutions. Mar Drugs 6:158. 10.3390/md15060158 [DOI] [PMC free article] [PubMed] [Google Scholar]
- 8.Serwecińska L (2020) Antimicrobials and antibiotic-resistant bacteria: a risk to the environment and to public health. Water 12:3313. 10.3390/w12123313 [Google Scholar]
- 9.Cabello FC, Godfrey HP, Tomova A, Ivanova L, Dölz H, Millanao A, Buschmann AH (2013) Antimicrobial use in aquaculture re-examined: its relevance to antimicrobial resistance and to animal and human health. Environ Microbiol 15:1917–1942. 10.1111/1462-2920.12134 [DOI] [PubMed] [Google Scholar]
- 10.Dharmaraj R, Sami S, Tharifkhan SA (2017) Effects of the potential probiotics Bacillus aerophilus KADR3 in inducing immunity and disease resistance in Labeo rohita. Fish Shellfish Immunol 70:408–415. 10.1016/j.fsi.2017.09.037 [DOI] [PubMed] [Google Scholar]
- 11.Gong L, He H, Li D, Cao L, Khan TA, Li Y, Pan L, Yan L, Ding X, Sun Y, Zhang Y, Yi G, Hu S, Xia L (2019) A new isolate of Pediococcus pentosaceus (SL001) with antibacterial activity against fish pathogens and potency in facilitating the immunity and growth performance of grass carps. Front Microbiol 27:1384. 10.3389/fmicb.2019.01384 [DOI] [PMC free article] [PubMed] [Google Scholar]
- 12.Zhou P, Chen W, Zhu Z, Zhou K, Luo S, Hu S, Xia L, Ding X (2022) Comparative study of Bacillus amyloliquefaciens X030 on the intestinal flora and antibacterial activity against Aeromonas of grass carp. Front Cell Infect Microbiol 25:815436. 10.3389/fcimb.2022.815436 [DOI] [PMC free article] [PubMed] [Google Scholar]
- 13.Balcazar JL, de Blas I, Ruiz-Zarzuela I, Cunningham D, Vendrell D, Muzquiz JL (2006) The role of probiotics in aquaculture. Vet Microbiol 114:173–186. 10.1016/j.vetmic.2006.01.009 [DOI] [PubMed] [Google Scholar]
- 14.Akhter N, Wu B, Memon AM, Mohsin M (2015) Probiotics and prebiotics associated with aquaculture: a review. Fish Shellfish Immunol 45:733–741. 10.1016/j.fsi.2015.05.038 [DOI] [PubMed] [Google Scholar]
- 15.Falcinelli S, Picchietti S, Rodiles A, Cossignani L, Merrifield DL, Taddei AR, Maradonna F, Olivotto I, Gioacchini G, Carnevali O (2015) Lactobacillus rhamnosus lowers zebrafish lipid content by changing gut microbiota and host transcription of genes involved in lipid metabolism. Sci Rep 30:9336. 10.1038/srep09336 [DOI] [PMC free article] [PubMed] [Google Scholar]
- 16.Harikrishnan R, Balasundaram C, Heo MS (2010) Lactobacillus sakei BK19 enriched diet enhances the immunity status and disease resistance to streptococcosis infection in kelp grouper. Epinephelus bruneus Fish Shellfish Immunol 29:1037–1043. 10.1016/j.fsi.2010.08.017 [DOI] [PubMed] [Google Scholar]
- 17.Thankappan B, Ramesh D, Ramkumar S, Natarajaseenivasan K, Anbarasu K (2015) Characterization of Bacillus spp. from the gastrointestinal tract of Labeo rohita–towards to identify novel probiotics against fish pathogens. Appl Biochem Biotechnol 175(1):340–53. 10.1007/s12010-014-1270-y [DOI] [PubMed] [Google Scholar]
- 18.Cao L, Pan L, Gong L, Yang Y, He H, Li Y, Peng Y, Li D, Yan L, Ding X, Hu S, Yu Z, Sun Y, Huang W, Hu Y, Yi G, Xia L (2019) Interaction of a novel Bacillus velezensis (BvL03) against Aeromonas hydrophila in vitro and in vivo in grass carp. Appl Microbiol Biotechnol 103:8987–8999. 10.1007/s00253-019-10096-7 [DOI] [PubMed] [Google Scholar]
- 19.Im SM, Yu NH, Joen HW, Kim SO, Park HW, Park AR, Kim JC (2020) Biological control of tomato bacterial wilt by oxydifficidin and difficidin-producing Bacillus methylotrophicus DR-08. Pestic Biochem Physiol 163:130–137. 10.1016/j.pestbp.2019.11.007 [DOI] [PubMed] [Google Scholar]
- 20.Mongkolthanaruk W (2012) Classification of Bacillus beneficial substances related to plants, humans and animals. J Microbiol Biotechnol 22:1597–1604. 10.4014/jmb.1204.04013 [DOI] [PubMed] [Google Scholar]
- 21.Molohon KJ, Saint-Vincent PMB, Park S, Doroghazi JR, Maxson T, Hershfield JR, Flatt KM, Schroeder NE, Ha T, Mitchell DA (2016) Plantazolicin is an ultra-narrow spectrum antibiotic that targets the Bacillus anthracis membrane. ACS Infect Dis 10:207–220. 10.1021/acsinfecdis.5b00115 [DOI] [PMC free article] [PubMed] [Google Scholar]
- 22.Jin P, Wang H, Tan Z, Xuan Z, Dahar GY, Li QX, Miao W, Liu W (2020) Antifungal mechanism of bacillomycin D from Bacillus velezensis HN-2 against Colletotrichum gloeosporioides Penz. Pestic Biochem Physiol 163:102–107. 10.1016/j.pestbp.2019.11.004 [DOI] [PubMed] [Google Scholar]
- 23.Lu LY, Zhou K, Huang WT, Zhou P, Yang S, Zhao X, Xie J, Xia L, Ding X (2019) A comprehensive genomic and growth proteomic analysis of antitumor lipopeptide bacillomycin Lb biosynthesis in Bacillus amyloliquefaciens X030. Appl Microbiol Biotechnol 18:7647–7662. 10.1007/s00253-019-10019-6 [DOI] [PubMed] [Google Scholar]
- 24.Zhao H, Shao D, Jiang C, Shi J, Li Q, Huang Q, Rajoka MSR, Yang H, Jin M (2017) Biological activity of lipopeptides from Bacillus. Appl Microbiol Biotechnol 15:5951–5960. 10.1007/s00253-017-8396-0 [DOI] [PubMed] [Google Scholar]
- 25.Zhou P, Huang H, Lu J, Zhu Z, Xie J, Xia L, Luo S, Zhou K, Chen W, Ding X (2021) The mutated Bacillus amyloliquefaciens strain shows high resistance to Aeromonas hydrophila and Aeromonas veronii in grass carp. Microbiol Res 250:126801. 10.1016/j.micres.2021.126801 [DOI] [PubMed] [Google Scholar]
- 26.Gomes ES, Schuch V, de Macedo Lemos EG (2014) Biotechnology of polyketides: new breath of life for the novel antibiotic genetic pathways discovery through metagenomics. Braz J Microbiol 44:1007–1034. 10.1590/s1517-83822013000400002 [DOI] [PMC free article] [PubMed] [Google Scholar]
- 27.McDaniel R, Ebert-Khosla S, Hopwood DA, Khosla C (1993) Engineered biosynthesis of novel polyketides. Science 5139:1546–1550. 10.1126/science.8248802 [DOI] [PubMed] [Google Scholar]
- 28.Zimmerman SB, Schwartz CD, Monaghan RL, Pelak BA, Weissberger B, Gilfillan EC, Mochales S, Hernandez S, Currie SA, Tejera E et al (1987) Difficidin and oxydifficidin: novel broad spectrum antibacterial antibiotics produced by Bacillus subtilis. I. Production, taxonomy and antibacterial activity. J Antibiot 40(12):1677–81. 10.7164/antibiotics.40.1677 [DOI] [PubMed] [Google Scholar]
- 29.Chakraborty K, Kizhakkekalam VK, Joy M, Dhara S (2021) Difficidin class of polyketide antibiotics from marine macroalga-associated Bacillus as promising antibacterial agents. Appl Microbiol Biotechnol 15–16:6395–6408. 10.1007/s00253-021-11390-z [DOI] [PubMed] [Google Scholar]
- 30.Wu L, Wu H, Chen L, Yu X, Borriss R, Gao X (2015) Difficidin and bacilysin from Bacillus amyloliquefaciens FZB42 have antibacterial activity against Xanthomonas oryzae rice pathogens. Sci Rep 13:12975. 10.1038/srep12975 [DOI] [PMC free article] [PubMed] [Google Scholar]
- 31.Kan J, Morales A, Hernandez Y, Ternei MA, Lemetre C, Maclntyre LW, Biais N, Brady SF (2024) Oxydifficidin, a potent Neisseria gonorrhoeae antibiotic due to DedA assisted uptake and ribosomal protein RplL sensitivity. bioRxiv 27:596031. 10.1101/2024.05.27.596031 [DOI] [PMC free article] [PubMed]
- 32.Matsuda Y, Imamura R, Takahara S (2017) Evaluation of antigen-specific IgM and IgG production during an in vitro peripheral blood mononuclear cell culture assay. Front Immunol 10:794. 10.3389/fimmu.2017.00794 [DOI] [PMC free article] [PubMed] [Google Scholar]
- 33.Li Y, Hu S, Gong L, Pan L, Li D, Cao L, Khan TA, Yang Y, Peng Y, Ding X, Yi G, Liu S, Xia L (2020) Isolating a new Streptomyces amritsarensis N1–32 against fish pathogens and determining its effects on disease resistance of grass carp. Fish Shellfish Immunol 98:632–640. 10.1016/j.fsi.2019.10.038(oldwas37) [DOI] [PubMed] [Google Scholar]
- 34.Zhang J, Kobert K, Flouri T, Stamatakis A (2014) PEAR: a fast and accurate Illumina Paired-End reAd merger. Bioinformatics 30:614–20. 10.1093/bioinformatics/btt593 (old was 33) [DOI] [PMC free article] [PubMed]
- 35.Rognes T, Flouri T, Nichols B, Quince C, Mahé F (2016) VSEARCH: a versatile open source tool for metagenomics. Peer J 18:2584. 10.7717/peerj.2584 (old was 34) [DOI] [PMC free article] [PubMed]
- 36.Edgar RC (2013) UPARSE: highly accurate OTU sequences from microbial amplicon reads. Nat Methods 10:996–998. 10.1038/nmeth.2604 [DOI] [PubMed] [Google Scholar]
- 37.Caporaso JG, Kuczynski J, Stombaugh J, Bittinger K, Bushman FD et al (2010) QIIME allows analysis of high-throughput community sequencing data. Nat Methods 7:335–336. 10.1038/nmeth.f.303 [DOI] [PMC free article] [PubMed] [Google Scholar]
- 38.Pu W, Wang Y, Yang N, Guo G, Li H, Li Q, Ur Rehman N, Zheng L, Wang P, Han S, Zhou CC, Zheng J, Zeng J, Yuan J (2020) Investigation of Streptococcus agalactiae using pcsB-based LAMP in milk, tilapia and vaginal swabs in Haikou, China. J Appl Microbiol 128:784–793. 10.1111/jam.14501 [DOI] [PubMed] [Google Scholar]
- 39.Wikler MA (2006) Performance standards for antimicrobial disk susceptibility tests: approved standard. Clin Lab Standards Inst 9:52 [Google Scholar]
- 40.Wang M, Yu H, Li X, Shen Z (2020) Single-gene regulated non-spore-forming Bacillus subtilis: construction, transcriptome responses, and applications for producing enzymes and surfactin. Metab Eng 62:235–248. 10.1016/j.ymben.2020.08.008 [DOI] [PubMed] [Google Scholar]
- 41.Han VC, Yu NH, Yoon H, Ahn NH, Son YK, Lee BH, Kim JC (2022) Identification, characterization, and efficacy evaluation of Bacillus velezensis for shot-hole disease biocontrol in flowering cherry. Plant Pathol J. 10.5423/PPJ.OA.01.2022.0004 [DOI] [PMC free article] [PubMed] [Google Scholar]
- 42.Gao XY, Liu Y, Miao LL, Li EW, Sun GX, Liu Y, Liu ZP (2017) Characterization and mechanism of anti-Aeromonas salmonicida activity of a marine probiotic strain, Bacillus velezensis V4. Appl Microbiol Biotechnol 101(9):3759–3768. 10.1007/s00253-017-8095-x [DOI] [PubMed] [Google Scholar]
- 43.Xie JJ, Liu QQ, Liao S, Fang HH, Yin P, Xie SW, Tian LX, Liu YJ, Niu J (2019) Effects of dietary mixed probiotics on growth, non-specific immunity, intestinal morphology and microbiota of juvenile pacific white shrimp, Litopenaeus vannamei. Fish Shellfish Immunol 90:456–465. 10.1016/j.fsi.2019.04.301 [DOI] [PubMed] [Google Scholar]
- 44.Nguyen TL, Chun WK, Kim A, Kim N, Roh HJ, Lee Y, Yi M, Kim S, Park CI, Kim DH (2018) Dietary probiotic effect of Lactococcus lactis WFLU12 on low-molecular-weight metabolites and growth of olive flounder (Paralichythys olivaceus). Front Microbiol 9:2059. 10.3389/fmicb.2018.02059 [DOI] [PMC free article] [PubMed] [Google Scholar]
- 45.Zuo ZH, Shang BJ, Shao YC, Li WY, Sun JS (2019) Screening of intestinal probiotics and the effects of feeding probiotics on the growth, immune, digestive enzyme activity and intestinal flora of Litopenaeus vannamei. Fish Shellfish Immunol 86:160–168. 10.1016/j.fsi.2018.11.003 [DOI] [PubMed] [Google Scholar]
- 46.Wang M, Lv C, Chen Y, Bi X, Yang D, Zhao J (2022) Effects of the potential probiotic Bacillus subtilis D1–2 on growth, digestion, immunity and intestinal flora in juvenile sea cucumber, Apostichopus japonicus. Fish Shellfish Immunol 124:12–20. 10.1016/j.fsi.2022.03.043 [DOI] [PubMed] [Google Scholar]
- 47.Etyemez MB, Cengizler I, Balcázar JL, Demirkale I (2023) Effects of two host-associated probiotics Bacillus mojavensis B191 and Bacillus subtilis MRS11 on growth performance, intestinal morphology, expression of immune-related genes and disease resistance of Nile tilapia (Oreochromis niloticus) against Streptococcusiniae. Dev Comp Immunol 138:104553. 10.1016/j.dci.2022.104553 [DOI] [PubMed] [Google Scholar]
- 48.Xiaolong G, Caihuan K, Fucun W, Xian L, Ying L (2020) Effects of Bacillus lincheniformis feeding frequency on the growth, digestion and immunity of Haliotis discus hannai. Fish Shellfish Immunol 96:1–12. 10.1016/j.fsi.2019.11.038 [DOI] [PubMed] [Google Scholar]
- 49.Sadat Hoseini Madani N, Adorian TJ, Ghafari Farsani H, Hoseinifar SH (2018) The effects of dietary probiotic bacilli (Bacillus subtilis and Bacillus licheniformis) on growth performance, feed efficiency, body composition and immune parameters of whiteleg shrimp (Litopenaeus vannamei) postlarvae. Aquaculture Res 49:1926–1933. 10.1111/are.13648 [Google Scholar]
- 50.Dawood MA, Koshio S (2016) Recent advances in the role of probiotics and prebiotics in carp aquaculture: a review. Aquaculture 454:243–251. 10.1016/j.aquaculture.2015.12.033 [Google Scholar]
- 51.Ringo E, Hoseinifar SH, Ghosh K, Doan HV, Beck BR, Song SK (2018) Lactic acid bacteria in finfish–an update. Front Microbiol 9:1818. 10.3389/fmicb.2018.01818 [DOI] [PMC free article] [PubMed] [Google Scholar]
- 52.Zhu Y, Li W, Zhang M, Zhong Z, Zhou Z, Han J, Zhang C, Yang J, Wu Y, Shu H (2023) Screening of host gut-derived probiotics and effects of feeding probiotics on growth, immunity, and antioxidant enzyme activity of hybrid grouper (Epinephelus fuscoguttatus♀ × E. lanceolatus♂). Fish Shellfish Immunol 136: 108700. 10.1016/j.fsi.2023.108700 [DOI] [PubMed]
- 53.Akbari H, Shekrabi SPH, Soltani M, Mehrgan MS (2021) Effects of potential probiotic Enterococcus casseliflavus (EC-001) on growth performance, immunity, and resistance to Aeromonas hydrophila infection in common carp (Cyprinus carpio). Probiotics Antimicrob Proteins 5:1316–1325. 10.1007/s12602-021-09771-x [DOI] [PubMed] [Google Scholar]
- 54.Muñoz-Atienza E, Araújo C, Magadán S, Hernández PE, Herranz C, Santos Y, Cintas LM (2014) In vitro and in vivo evaluation of lactic acid bacteria of aquatic origin as probiotics for turbot (Scophthalmus maximus L.) farming. Fish Shellfish Immunol 2:570–580. 10.1016/j.fsi.2014.10.007 [DOI] [PubMed] [Google Scholar]
- 55.Wang X, Zhang P, Zhang X (2021) Probiotics regulate gut microbiota: an effective method to improve immunity. Molecules 19:6076. 10.3390/molecules26196076 [DOI] [PMC free article] [PubMed] [Google Scholar]
- 56.Luan L, Li M, Zhou W, Yao Y, Yang Y, Zhang Z, Ringø E, Olsen RE, Clarke JK, Xie S, Mai K (2023) The fish microbiota: research progress and potential applications. Engineering 29:2095–8099. 10.1016/j.eng.2022.12.011 [Google Scholar]
- 57.Ackerman PA, Iwama GK, Thornton JC (2000) Physiological and immunological effects of adjuvanted Aeromonas salmonicida vaccines on juvenile rainbow trout. J Aquat Anim Health 12(2):157–164. 10.1111/raq.12317 [Google Scholar]
- 58.Preidis GA, Versalovic J (2009) Targeting the human microbiome with antibiotics, probiotics, and prebiotics: gastroenterology enters the metagenomics era. Gastroenterology 136(6):2015–2031. 10.1053/j.gastro.2009.01.072 [DOI] [PMC free article] [PubMed] [Google Scholar]
- 59.Kakade A, Salama ES, Pengya F, Liu P, Li X (2020) Long-term exposure of high concentration heavy metals induced toxicity, fatality, and gut microbial dysbiosis in common carp Cyprinus carpio. Environ Pollut 3:115293. 10.1016/j.envpol.2020.115293 [DOI] [PubMed] [Google Scholar]
- 60.Binda C, Lopetuso LR, Rizzatti G, Gibiino G, Cennamo V, Gasbarrini A (2018) Actinobacteria: a relevant minority for the maintenance of gut homeostasis. Dig Liver Dis 5:421–428. 10.1016/j.dld.2018.02.012 [DOI] [PubMed] [Google Scholar]
- 61.Sha Y, Liu M, Wang B, Jiang K, Qi C, Wang L (2016) Bacterial Population in Intestines of Litopenaeus vannamei Fed Different Probiotics or Probiotic Supernatant. J Microbiol Biotechnol 26(10):1736–1745. 10.4014/jmb.1603.03078 [DOI] [PubMed] [Google Scholar]
- 62.Duman M, García Valdés E, Ay H, Altun S, Saticioglu IB (2023) Description of a novel fish pathogen, Plesiomonas shigelloides subsp. oncorhynchi, isolated from rainbow trout (Oncorhynchus mykiss): first genome analysis and comparative genomics. Fishes 8:(4)179. 10.3390/fishes8040179
- 63.Li B, Sun LW, Wu YT (2017) Intestinal flora and protein metabolism. Chin J Microecology 6:739–741 [Google Scholar]
- 64.Bera AK, Chowdhury H, Ghatak S, Malick RC, Chakraborty N, Chakraborty HJ, Swain HS, Hassan MA, Das BK (2023) Microbiome analysis reveals potential for modulation of gut microbiota through polysaccharide-based prebiotic feeding in Oreochromis niloticus (Linnaeus, 1758). Front Physiol 14:1168284. 10.3389/fphys.2023.1168284 [DOI] [PMC free article] [PubMed] [Google Scholar]
- 65.Zheng M, Zhang R, Tian X, Zhou X, Pan X, Wong A (2017) Assessing the risk of probiotic dietary supplements in the context of antibiotic resistance. Front Microbiol 19(8):908. 10.3389/fmicb.2017.00908 [DOI] [PMC free article] [PubMed] [Google Scholar]
Associated Data
This section collects any data citations, data availability statements, or supplementary materials included in this article.
Supplementary Materials
Data Availability Statement
The data of the manuscript is previously unpublished. The 16S rRNA gene sequence is available in the NCBI database (Accession No: PP989326), while reads of gut microbiota are available in the NCBI Short Read Archive database (Accession No. PRJNA1133171).
PRJNA1133171.